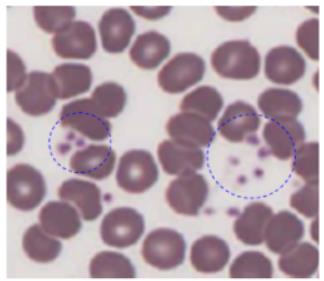
Platelets in a blood smear

BackCardiovascular System: Blood, Blood Vessels, and Heart - Study Notes
Study Guide - Smart Notes
Tailored notes based on your materials, expanded with key definitions, examples, and context.
Blood
Functions of Blood
Blood is essential for the survival of cells and organs, performing several critical functions:
Transport: Carries oxygen from the lungs to tissues and removes carbon dioxide from tissues to the lungs for exhalation.
Regulation: Maintains body temperature and pH levels within a narrow range (7.35–7.45).
Protection: Facilitates immune responses, with white blood cells migrating to sites of infection.
Physical Characteristics of Blood
Viscosity: Four times thicker than water, similar to maple syrup.
Temperature: Approximately 38ºC.
Volume: Average adult has about 5 liters.
Components of Blood
Blood consists of two main components:
Plasma: Makes up 55% of blood volume; 92% water, 8% solutes (including plasma proteins, electrolytes, nutrients, and wastes).
Formed Elements: Comprise 45% of blood; include erythrocytes, thrombocytes, and leukocytes.
Erythrocytes (Red Blood Cells)
Contain hemoglobin for oxygen and carbon dioxide transport.
Lack nuclei; 8 μm diameter, 2 μm thick; lifespan ~120 days.
Thrombocytes (Platelets)
Smallest formed elements; function in hemostasis (stopping bleeding).
Lack nuclei; 2–4 μm diameter; originate from megakaryocytes in red bone marrow.
Leukocytes (White Blood Cells)
Have nuclei; do not contain hemoglobin.
Divided into granulocytes and agranulocytes.
Granulocytes
Granulocytes are leukocytes with granules in their cytoplasm and segmented nuclei. There are three types:
Neutrophils: 60–70% of WBCs; first line of defense against bacteria; phagocytic; nucleus with 2–6 lobes; small neutral granules.
Eosinophils: 2–4% of WBCs; defend against allergic reactions and parasitic infections; bilobed nucleus; granules stain pinkish-red.
Basophils: <1% of WBCs; release heparin and histamine during inflammation/allergy; nucleus with 2–3 irregular lobes obscured by dark granules.

Granulocytes Review Chart
Cell Type | Granules/Cytoplasm | Nucleus | Other Information |
|---|---|---|---|
Neutrophil | Small, neutral granules | 2–6 lobes | Phagocytic, defense against bacteria |
Eosinophil | Large, pinkish-red granules | Bilobed | Defense against allergy/parasitic infection |
Basophil | Dark granules (heparin, histamine) | 2–3 irregular lobes | Inflammatory/allergic response |
Agranulocytes
Agranulocytes lack granules in their cytoplasm and have round or indented nuclei. There are two types:
Lymphocytes: 20–30% of WBCs; attack pathogens and abnormal cells; large, dark nucleus; cytoplasm appears as a narrow rim.
Monocytes: 3–8% of WBCs; large size (16–20 μm); nucleus oval or kidney-bean shaped; cytoplasm pale blue and abundant; become macrophages in tissues.

Agranulocytes Review Chart
Cell Type | Cytoplasm | Nucleus | Other Information |
|---|---|---|---|
Lymphocyte | Pale, halo around nucleus | Large, dark | Attacks pathogens/abnormal cells |
Monocyte | Pale blue, abundant | Oval/bean shaped | Becomes macrophage outside blood |
Functions of Blood Cells Review
Blood Cell | Main Function |
|---|---|
Lymphocyte | Attack pathogens and abnormal cells |
Erythrocyte | Transport oxygen and carbon dioxide |
Eosinophil | Defense against allergic/parasitic reactions |
Thrombocyte | Hemostasis |
Neutrophil | First line of defense against bacteria |
Basophil | Release histamine and heparin |
Monocyte | Phagocytic outside blood stream |
Blood Vessels
Structure of Blood Vessels
Blood vessels are composed of three tunics (layers):
Tunica Externa (Adventitia): Outer layer; connective tissue with collagen and elastic fibers.
Tunica Media: Middle layer; smooth muscle and elastic fibers.
Tunica Intima: Inner lining; simple squamous epithelium (endothelium).

Types of Blood Vessels
Elastic Arteries: Large arteries near the heart (e.g., aorta); large lumen; tunica media rich in elastic fibers; stretch and recoil.
Muscular Arteries: Deliver blood to organs; thick tunica media with smooth muscle; contractile.
Arterioles: Lead to capillaries; larger arterioles have three tunics, smaller have a single layer of smooth muscle.
Capillaries: Smallest vessels (8–10 μm); only tunica intima and basement membrane; site of exchange between blood and tissues.
Venules: Smallest venules have one tunic; larger venules have three thin tunics; larger lumen than capillaries.
Veins: Large lumen; less muscle in tunica media; contain one-way valves to prevent backflow.

Structure of Blood Vessels Review Table
Blood Vessel | Structural/Functional Features |
|---|---|
Elastic Artery | Tunica media has more elastic fibers; stretching and recoil |
Capillary | Only tunica intima and basement membrane |
Vein | Three tunics, large lumen, valves to prevent backflow |
Muscular Artery | Tunica media with lots of smooth muscle; contractile |
Venule | Three tunics but very thin |
Arteriole | Few to one layer of smooth muscle around endothelium |
The Heart
Distribution of Cardiac Output
The heart pumps blood throughout the body. At any time, 30–35% of blood is in the arterial system, while 65–70% is in the venous system.
Pulmonary and Systemic Circulation
Pulmonary Circulation: Carries deoxygenated blood from the heart to the lungs for oxygenation, then returns oxygenated blood to the heart.
Systemic Circulation: Carries oxygenated blood from the heart to tissues (except lungs), returns deoxygenated blood to the heart.
Anatomical Location of the Heart
The heart is located in the mediastinum, the space between the lungs in the thorax. Its shape resembles an inverted pear, with the apex as the most inferior and lateral portion.

Coverings of the Heart
Fibrous Pericardium: Most external protective covering.
Serous Pericardium: Divided into parietal and visceral layers, with pericardial fluid between them to reduce friction.

Chambers of the Heart
The heart has four chambers: right atrium, left atrium, right ventricle, left ventricle.

The Atria of the Heart
Interatrial Septum: Wall between left and right atria; contains the fossa ovalis.
Fossa Ovalis: Depression in the interatrial septum; remnant of fetal foramen ovale.
Auricles: Extensions above atria, increasing capacity.
Atrioventricular Groove (Coronary Sulcus): Depression separating atria from ventricles; houses coronary vessels.

The Ventricles of the Heart
Right Ventricle: Pumps blood to lungs for oxygenation.
Left Ventricle: Pumps oxygenated blood to the body.
Interventricular Sulcus: Groove separating right and left ventricles externally.
Interventricular Septum: Wall between left and right ventricles.
Trabeculae Carneae: Irregular muscular ridges inside ventricles.
Papillary Muscles: Muscular projections attaching to heart valves.

Valves of the Heart
Tricuspid Valve: Between right atrium and right ventricle; has chordae tendinae attached to papillary muscles.
Bicuspid (Mitral) Valve: Between left atrium and left ventricle; also anchored by chordae tendinae.
Aortic Semilunar Valve: Between left ventricle and aorta; controls blood flow to systemic circulation.
Pulmonary Semilunar Valve: Between right ventricle and pulmonary trunk; controls blood flow to pulmonary circulation.

Clinical Application: Heart Ultrasound
Cardiac ultrasound (echocardiogram) allows visualization of the heart's internal anatomy and valve function. It is used to diagnose heart and valve diseases.

Great Vessels Draining Blood into the Heart
Pulmonary Veins: Drain oxygenated blood from lungs to left atrium.
Superior Vena Cava: Drains deoxygenated blood from upper body to right atrium.
Coronary Sinus: Drains deoxygenated blood from coronary circulation to right atrium.
Inferior Vena Cava: Drains deoxygenated blood from lower body to right atrium.

Great Vessels Pumping Blood Away from the Heart
Ascending Aorta: Conducts oxygenated blood from left ventricle to body.
Pulmonary Trunk: Conducts deoxygenated blood from right ventricle to pulmonary arteries.
Pulmonary Arteries: Conduct deoxygenated blood from pulmonary trunk to lungs.

Tracing the Flow of Blood Through the Heart
Superior and inferior vena cava and coronary sinus
Right atrium
Tricuspid valve
Right ventricle
Pulmonary semilunar valve
Pulmonary trunk
Pulmonary arteries
Lungs
Pulmonary veins
Left atrium
Bicuspid valve
Left ventricle
Aortic semilunar valve
Aorta
Arterial Supply of the Heart (Coronary Circulation)
Right Coronary Artery: Supplies right side of heart; branches include right marginal and posterior interventricular arteries.
Left Coronary Artery: Supplies left side of heart; branches include circumflex and anterior interventricular arteries.
Venous Drainage of the Heart
Tributaries return deoxygenated blood to the right atrium via the coronary sinus.
Clinical Application – Heart Attack Case Study
Left Coronary Artery Blockage: Most affects the left ventricle, anterior interventricular septum, and left atrium.
Impact: If the left ventricle is compromised, the body receives less oxygenated blood, impairing function.
Conclusion
The cardiovascular system supplies blood to organs, tissues, and cells. Understanding the structure and function of blood, blood vessels, and the heart is essential for medical terminology and clinical practice.